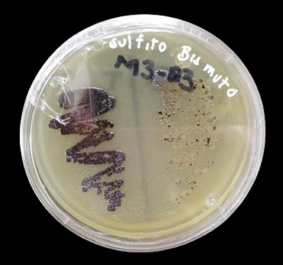
Crecimiento de colonias de Salmonella spp. sobre agar sulfito de bismuto.

CIENCIAS AGROPECUARIAS
Análisis microbiológico de harina de grillo de una marca comercial mexicana
Microbiological analysis of cricket flour from a Mexican commercial brand
Análisis microbiológico de harina de grillo de una marca comercial mexicana
Investigación y Ciencia, vol. 32, núm. 92, pp. 1-12, 2024
Universidad Autónoma de Aguascalientes
Recepción: 12 Mayo 2023
Aprobación: 22 Febrero 2024
Publicación: 31 Mayo 2024
Resumen: Los insectos como parte de la alimentación humana han tenido gran auge en los últimos años dadas las ventajas que ofrecen, tanto nutricionales como su impacto mínimo al medio ambiente. Al ser una fuente alternativa de alimentación relativamente nueva para la mayoría de la población del mundo, aún no se encuentra regulada en lo que a su producción, procesamiento y comercialización respecta; por lo que tampoco existen protocolos que aseguren la inocuidad de los mismos. En este estudio se realizó un análisis microbiológico a una marca comercial de harina de grillo (Acheta domesticus L.) disponible en plataformas de venta en línea en México. Se analizaron tres lotes distintos y se obtuvieron conteos por debajo de los límites señalados por la NOM-247-SSA1-2008 de mesófilos aerobios y de mohos; las pruebas para coliformes totales y fecales resultaron negativas y se detectó la presencia de Salmonella spp.
Palabras clave: insectos comestibles, harina de grillo, inocuidad.
Abstract: Insects as part of the human diet boomed in recent years given the advantages they offer, both nutritional and for the environment. Being a relatively new alternative source of food for the majority of the world's population, their production, processing and commercialization are still not regulated; so, there are no protocols that ensure their safety. In this study, a microbiological analysis was carried out on a commercial brand of cricket flour (Acheta domesticus L.) available on online sales platforms in Mexico. Three different batches were analyzed and counts below the limits indicated by NOM-247-SSA1-2008 of aerobic mesophilic and molds were obtained; the tests for total and fecal coliforms were negative and the presence of Salmonella spp. was detected.
Keywords: edible insects, cricket flour, safety.
INTRODUCCIÓN
La ingesta de insectos como parte de la alimentación humana o entomofagia es una práctica ancestral muy arraigada en diferentes culturas de África, América, Asia y Oceanía; más de 2,000 especies de insectos forman parte de la dieta humana en el mundo (Fernandez-Cassi et al., 2019; Jongema, 2017). En México se tiene evidencia del consumo de insectos desde antes de la conquista, con ellos se elaboran platillos muy variados, algunos incluso considerados gourmets (Viesca González & Romero Contreras, 2009); pese a ello esta costumbre se ha perdido en algunas regiones del país, pero está muy presente en culturas del centro y sur (García-Ramírez, Valdez-Gutiérrez, & López-Toledo, 2022; Viesca González & Romero Contreras, 2009).
Algunos factores como el cambio climático, la contaminación, el incremento poblacional y el agotamiento de recursos naturales obligan al desarrollo de nuevas tecnologías, métodos de producción y alimentos innovadores que sean sustentables, de calidad y seguros (Caparros Megido et al., 2017). Los retos para satisfacer las necesidades de alimentación para la población humana son cada vez más complejos; se estima que para el año 2050 se debe incrementar 70% la producción de alimentos (Fernandez-Cassi et al., 2019; Food and Agriculture Organisation, 2009). El consumo de insectos y sus productos derivados representan una opción viable para afrontar estos retos al presentar múltiples ventajas como una alta tasa de reproducción, ciclos de vida cortos, el uso de una cantidad de agua considerablemente menor que la utilizada en la producción de carne; además de un reducido uso de suelo, bajas emisiones de gases de efecto invernadero y su alto valor nutricional (Imathiu, 2020). Los insectos comestibles presentan un alto contenido de proteína que varía desde 19 hasta 60g/100 g de porción (Belluco et al., 2013; Van Huis, 2015), en cuanto al contenido de grasa es comparable con los ácidos grasos encontrados en el pescado con bajo contenido de colesterol (DeFoliart, 1991; Imathiu, 2020; Ritter, 1990), también representan una fuente importante de vitaminas y minerales (Köhler, Kariuki, Lambert, & Biesalski, 2019).
Al ser un alimento relativamente nuevo en su producción a gran escala (o para la mayor parte de la población), existe un desconocimiento en cuanto a los posibles contaminantes que pudieran poner en riesgo la salud de los consumidores; de acuerdo con Murefu, Macheka, Musundire y Manditsera (2019) estos riesgos pueden ser químicos, biológicos y alérgenos. En cuanto a los riesgos biológicos, patógenos pueden atacar a vertebrados e invertebrados de forma natural (Grabowski & Klein, 2017a), lo que significa un riesgo potencial para el consumidor. Los estudios para determinar los posibles contaminantes en insectos comestibles y sus derivados son aún escasos; sin embargo, existen algunos trabajos que reportan la presencia de enterobacterias en insectos comestibles recolectados de ecosistemas silvestres, también en aquellos provenientes de crías bajo condiciones controladas (Grabowski & Klein, 2017b; Fernandez-Cassi et al., 2019).
En México los trabajos con respecto a los insectos comestibles son insuficientes y la mayoría enfocados a análisis nutricionales y métodos de producción (Corredor-Bejar, 2022; Navarro-Cruz, Ávila-Sosa, Aguilar-Alonso, Vera-López, & Dávila Márquez, 2011). En cuanto a la inocuidad de estos alimentos se encuentran un estudio realizado a platillos con gusano rojo del agave (Ramos-Rostro et al., 2016) y el realizado a un yogurt adicionado con harina de grillo (Arnaud-López, Cuateco-Hueyopa, & Ortega-Morales, 2022), ambos estudios con resultados positivos para el consumidor; en el primero, los conteos realizados fueron bajos y en el segundo se logró reducir la carga bacteriana con el uso de diferentes técnicas. Es importante determinar contaminantes y/o patógenos propios de las especies a consumir para garantizar la seguridad de ingesta.
La importancia de implementar leyes o normas que regulen y evalúen la seguridad de los alimentos con base en insectos ha sido resaltada en divesrsos trabajos; en México García-Ramírez et al. (2022) mencionan que productos derivados de los mismos que se venden en mercados requieren de especial atención y control. En otras partes del mundo se valora la riqueza nutricional y el potencial aporte para la seguridad alimentaria que representan estos alimentos, pero se resalta la necesidad de que dichos productos pasen por pruebas y se establezcan estándares que aseguren su inocuidad antes de ser puestos en el mercado (Fernandez-Cassi et al., 2019; Imathiu, 2020; Van der Fels-Klerx, Camenzuli, Belluco, Meijer, & Ricci, 2018).
En México no existe regulación legal en cuanto a la producción de insectos para consumo humano, ni sobre los procesos, límites microbiológicos o presencia de ciertos microorganismos que pudieran ser de riesgo para la salud pública y/o ambiental (Ramos-Elorduy, Pino, & Conconi, 2006). La presencia de mesófilos aerobios, levaduras, mohos, Salmonella spp., coliformes totales y fecales; entre otros microorganismos frecuentemente detectados en alimentos son un indicador de la higiene y calidad del agua y los alimentos (Campuzano, Mejía-Florez, Madero-Ibarra, & Pabón Sánchez, 2015; Félix-Fuentes, Campas-Baypoli, & Meza-Montenegro, 2005).
Este estudio buscó contribuir con información sobre la inocuidad de productos comerciales para el consumo humano con base en insectos, por lo que el objetivo de la investigación fue determinar la presencia o ausencia de Salmonella spp., Escherichia coli, coliformes totales y fecales y el conteo de mesófilos aerobios, levaduras y mohos en harina del grillo Acheta domesticus L. (Orthoptera: Gryllidae) producida por una marca comercial mexicana.
MATERIALES Y MÉTODOS
Obtención de las muestras
Desde agosto hasta noviembre de 2022 se analizaron tres lotes diferentes que, de acuerdo con la etiqueta, se trataba de harina 100% de grillo A. domesticus L. sin ningún ingrediente adicional. El producto es de marca mexicana y se obtuvo a través de la compra en línea en tienda oficial. De acuerdo con el fabricante los productos analizados no contenían ningún saborizante, ni conservador añadido y se encontraban completamente cerrados y sellados.
Procesamiento
Los análisis realizados se llevaron a cabo de acuerdo con la Norma Oficial Mexicana (NOM) indicada en cada caso. Al no existir normas específicas para el procesamiento y análisis de productos de este tipo, se recurrió a las elaboradas para el análisis y detección de microorganismos en otros alimentos. La NOM-247-SSA1-2008 (Secretaría de Salud, 27 de julio de 2009) establece las especificaciones sanitarias para cereales y sus productos; entre estas harinas; en la misma se indica la necesidad de la realización de conteos de unidades formadoras de colonia (UFC) de mesófilos aerobios, coliformes totales y hongos y se establece el límite permitido para estos productos; por lo que se realizaron dichas pruebas.
Los lotes analizados presentaban números asignados por la marca, a los cuales se les designó un número más simple de identificación; el lote 0221172 se identificó como L1, el 0211112 como L2 y el 0211286 como L3; esto de acuerdo con el orden en el que se adquirieron. Para todas las pruebas se analizaron tres repeticiones por lote (R1, R2 y R3); se realizó un conteo de unidades formadoras de colonia de mesófilos aerobios, mohos y levaduras por cada lote y se realizaron pruebas para detectar la presencia o ausencia de Salmonella spp. y coliformes totales y fecales. Para el conteo de unidades formadoras de colonias de mesófilos aerobios por gramo se utilizó la metodología señalada por la NOM-092-SSA1-1994 (Secretaría de Salud, 12 de diciembre de 1995) en Agar Métodos Estándar (marca BD Bioxon ); para el conteo de UFC/g de mohos y levaduras se utilizaron los métodos contenidos en la NOM-111-SSA1-1994 (Secretaría de Salud, 13 de septiembre de 1995) en Agar Papa Dextrosa (BD Bioxon
); para el conteo de UFC/g de mohos y levaduras se utilizaron los métodos contenidos en la NOM-111-SSA1-1994 (Secretaría de Salud, 13 de septiembre de 1995) en Agar Papa Dextrosa (BD Bioxon ), estos análisis se realizaron en la Facultad de Ciencias Químicas de la Universidad de Colima en el Laboratorio de Bacteriología.
), estos análisis se realizaron en la Facultad de Ciencias Químicas de la Universidad de Colima en el Laboratorio de Bacteriología.
El resto de los análisis se llevaron a cabo en el Departamento de Parasitología Agrícola de la Universidad Autónoma Agraria Antonio Narro en el Laboratorio de Toxicología, se realizaron tres repeticiones de cada prueba de los tres lotes analizados. Para la detección de coliformes totales y fecales se utilizó caldo lactosado (marca TM Media®) como medio de preenriquecimiento, se colocaron 9 ml en tubos de ensayo de vidrio limpios, a los que se les introdujo una campana de Durham y se esterilizaron en una autoclave. Inicialmente se preparó una solución madre agregando 1 g de la muestra en 10 ml de agua destilada estéril y se mezcló perfectamente. Con una micropipeta se tomó 1 ml de la solución madre y se inoculó en tres tubos con caldo lactosado estéril y campana de Durham, se mezcló gentilmente y de cada tubo de esta dilución se tomó 1 ml y se inoculó en otros tres tubos; nuevamente de esta dilución se tomó 1 ml y se inoculó en tres tubos más; de esta manera se obtuvieron las diluciones 1/10, 1/100 y 1/1000. Todas las series se incubaron a 35 °C por 24 horas en una incubadora Barsnstead Lab line. Posteriormente para detectar la presencia de Escherichia coli se utilizó Agar Eosina y azul de metileno (EMB) de MCD Lab.
Para la detección de Salmonella spp. la metodología se basó en la NOM-114-SSA1-1994 (Secretaría de Salud, 22 de septiembre de 1995). Se utilizó caldo lactosado como medio de preenriquecimiento, los medios de enriquecimiento fueron selenito y tetrationato (marca TM Media®); para el aislamiento se utilizaron los medios selectivos Agar Verde Brillante (VB, TM Media®), Agar Salmonella-Shigella (SS, MCD Lab), Agar sulfito de bismuto (SB, TM Media®) y Agar xilosa lisina desoxicolato (XLD, MCD Lab). Se colocó 1 ml de solución madre en 10 ml de caldo lactosado estéril y se incubó a 35 °C por 24 horas, transcurrido este tiempo se tomó 1 ml y se inocularon tubos de ensayo con los medios de preenriquecimiento selenito y tetrationato y se colocaron en incubadora a 35 °C durante 48 horas.
La detección de la presencia sugestiva de Salmonella spp. se realizó a través de los medios selectivos ya mencionados para su aislamiento. Después del enriquecimiento en los medios selenito y tetrationato se realizó un estriado en cada uno de los medios selectivos y se incubaron a 35 °C, se revisaron después de 24 y 48 horas. Se consideró positivo aquellas cajas que presentaron crecimiento bacteriano con las características indicadas para Salmonella spp. por los fabricantes de cada medio. Los conteos en las repeticiones que presentaron desarrollo se analizaron mediante prueba t-Student, considerando una significancia estadística con un valor de p menor a 0.05 con el programa IBM SPSS Statistics.
RESULTADOS
Se detectó la presencia de mesófilos aerobios en dos de los lotes analizados (L2 y L3), en el L2 se contabilizaron 340 ± 5 UFC/g y en el L3 380 ± 1 UFC/g, el L1 fue negativo a la presencia de estos microorganismos; existieron diferencias significativas entre dichos lotes (t4(0.05)= 13.59, p= 0.002). Para mohos se contabilizaron 20 ± 5 UFC/g de mohos en el primer lote (L1) y los lotes 2 y 3 resultaron negativos a la presencia de mohos, en cuanto a levaduras los tres lotes resultaron negativos. Las pruebas para detección de coliformes totales y fecales de los tres lotes analizados en las tres repeticiones resultaron negativas.
Para Salmonella spp. en el L1 no se observó su presencia a excepción de la R1 en los medios SB y VB, inoculados a partir del medio de preenriquecimiento selenito. El L2 dio positivo en las tres repeticiones realizadas en SB a partir de los dos medios de preenriquecimiento (selenito y tetrationato), en el Agar VB se presentó crecimiento positivo en las tres repeticiones inoculadas a partir de selenito.
El L3 presentó crecimiento positivo a Salmonella spp. en las tres repeticiones a partir de los dos medios de enriquecimiento (selenito y tetrationato) en el Agar SB (figura 1) y VB; mientras que en el Agar SS presentó crecimiento positivo en las tres repeticiones inoculadas a partir de tetrationato y positivo sólo en la R2 a partir de selenito. En el Agar XLD fue negativo para Salmonella spp. en las tres repeticiones inoculadas a partir de los dos medios de enriquecimiento.
Figura 1.
Crecimiento de colonias de Salmonella spp. sobre agar sulfito de bismuto.
Fotografía tomada por el autor principal.
El número total de repeticiones analizadas para la detección de Salmonella spp. fue de 72 entre los cuatro medios selectivos y los tres lotes, de las cuales 27 dieron resultados positivos a la presencia de esta bacteria (tabla 1).

Nota: Elaboración propia.
DISCUSIÓN
Ya ha sido resaltada la ausencia de regulaciones con respecto a la inocuidad de los alimentos y productos con base en insectos; en este caso harina de grillo. Sin embargo, existe una norma oficial mexicana que establece los límites microbiológicos permitidos para harinas elaboradas a partir de distintos cereales; la NOM-247-SSA1-2008 (Secretaría de Salud, 27 de julio de 2009) en la que se señala un número máximo permitido de 50,000 UFC/g de mesófilos aerobios en harina de trigo, sémola o semolina y hasta 500,000 UFC/g en harinas integrales, por lo que el número de UFC contabilizadas en este estudio se encuentran muy por debajo del límite permitido en otras harinas; ya que el número más alto fue de 380 UFC/g que corresponde al tercer lote analizado, lo que representa un riesgo mínimo para la salud humana en lo que a estos microorganismos respecta.
El conteo de mesófilos aerobios obtenidos en este estudio fue inferior en comparación con los reportados en otras investigaciones realizadas en insectos comestibles, incluyendo A. domesticus. Ramos-Rostro et al. (2016) reportan un número de mesófilos aerobios de 800 y 27,000 UFC/g en muestras congeladas y frescas crudas de gusanos rojos de maguey Comadia redtembacheri H. (Lepdoptera: Cossidae), respectivamente. En muestras de gusanos cocinados detectaron entre 30 a 2800 UFC/g, dependiendo el método de cocción y preparación. Arango-Gutiérrez, Vergara-Ruiz y Mejía-Vélez (2004) reportan 1500 UFC/g en harina de larvas de Hermetia illuscens L. (Diptera: Stratiomydae), nivel que se encuentra dentro de los límites indicados en las normas colombianas. Grabowski y Klein (2017b) analizaron la carga microbiológica de diversas especies de insectos comestibles; vivos, muertos y sustrato, detectaron un número total de bacterias de 7.1 log UFC/g en A. domesticus, incluyendo enterobacterias y estafilococos; en ninguna de las muestras analizadas en dicho estudio se encontró la presencia de Salmonella spp. o E. coli.
Garofalo et al. (2017) obtuvieron un conteo de 4.01 a 4.50 log UFC/g de mesófilos aerobios en grillos enteros (A. domesticus) y de 3.91 a 4.8 log UFC/g en harina de grillo de la misma especie, detectaron un número de mesófilos aerobios menor (2.01 a 2.43 log UFC/g) en langostas enteras Locusta migratoria L. (Orthoptera: Acrididae). Caparros-Megido et al. (2017) analizaron grillos listos para consumo sometidos a tratamientos para disminuir la carga bacteriana; en las muestras sin tratamiento obtuvieron 7.97 log UFC/g; mientras que en las sometidas a procesos de esterilización se contabilizaron de 3.74 a 4.39 log UFC/g y en muestras liofilizadas se obtuvo un conteo total de 4.05 log UFC/g.
La NOM-247-SSA1-2008 (Secretaría de Salud, 27 de julio de 2009) establece para hongos o mohos un límite de 100 UFC/g en harina de avena y 1000 UFC/g en harinas de maíz; en la harina de grillo analizada en este estudio se obtuvieron únicamente 20 UFC/g sólo en el primer lote y no se detectó la presencia de levaduras, para las cuales no hay una indicación al respecto en dicha norma. En contraste, Garofalo et al. (2017), detectaron levaduras y hongos en grillos enteros y también en harina, algunos conteos con cantidades muy bajas ˂2.00 log CFU/g; en grillos enteros se contabilizaron de 4.52 a 5.10 log CFU/g de levaduras; mientras que en harina de grillo la presencia de levaduras fue muy baja y la de hongos fue de 2.92 a 3.10 log CFU/g. En investigaciones como la de Grabowski y Klein (2017b) la presencia de hongos y levaduras fue nula en grillos vivos (criados para consumo), pero en los sacrificados sí se encontraron en cantidades de 4 a 5.4 log UFC/g; algunos estudios indican que el método de sacrificio de los insectos influye en gran medida en la proliferación de microorganismos (Caparros-Megido et al., 2017); sin embargo, el producto analizado no especifica el método de sacrificio utilizado.
En este estudio no se encontró presencia de coliformes totales, ni de E. coli. De forma similar Akullo, Kiage-Mokua, Nakimbugwe, Ng´ang´a y Kinyuru (2023) reportan resultados negativos a la presencia de estas bacterias en harina del grillo Gryllus bimaculatus (Orthoptera: Gryllidae) tratada con extractos de jengibre y/o ajo, en el producto analizado en este estudio no se especifica si fue sometido a algún tratamiento para eliminar contaminantes. La NOM-247-SSA1-2008 (Secretaría de Salud, 27 de julio de 2009) establece el límite máximo de 500 UFC/g de coliformes totales en harinas de cereales integrales, en harina de avena sólo se permite 50 UFC/g. Grabowski y Klein (2017b) reportan la presencia de bacterias coliformes en chapulines procesados, así como la ausencia de E. coli en muestras de diversas especies de insectos comestibles; pero sí realizan conteo de otras enterobacterias. Müller et al. (2021) aislaron E. coli de 36 muestras de insectos para consumo humano; no obstante, en productos de grillo (A. domesticus) no se encontró.
Las intoxicaciones por la ingesta de alimentos en mal estado o contaminados usualmente son causadas por bacterias (Félix-Fuentes et al., 2005) que pueden llegar a causar síntomas muy severos e incluso la muerte en individuos vulnerables, éstos incluyen diarrea, nausea, vómito, fiebre, dolor abdominal, entre otros (Contreras-Soto et al., 2019; Mohammad, Chowdhury, Biswas, & Absar, 2018). Frentzel et al. (2022) indican la presencia de Salmonella enterica en productos de grillo. En este estudio dos de los tres lotes analizados dieron positivo a la presencia de Salmonella spp., que es una bacteria mesofílica y el conteo de dichos microorganismos fue muy bajo (máximo 380 UFC/g). En contraste, trabajos donde analizan especies de insectos comestibles incluyendo A. domesticus resaltan la ausencia de Salmonella spp. (Garofalo et al., 2017; Grabowski & Klein, 2017b; Osimani et al., 2017; Vandeweyer, Crauwels, Lievens, & VanCampenhout, 2017).
Un aspecto importante a considerar es el manejo de los insectos durante la cría, sacrificio y de modo posterior al sacrificio; ya que puede ocurrir contaminación por el hombre al carecer de prácticas adecuadas de higiene (Fernandez-Cassi et al., 2019), además del proceso de cocción (si existe alguno). Nyangena et al. (2020) resaltan la presencia de Salmonella spp. en insectos crudos de las especies A. domesticus, H. illucens y Ruspolia differens (Orthoptera: Tettigoniidae), cuyo resultado persiste después del secado solar o en horno de los insectos; mientras que los sometidos a una combinación de procedimientos como hervido y secado solar o en horno, tostado y secado solar o en horno resultaron negativos a la presencia de Salmonella spp.
Estos estudios revelan información importante para el establecimiento de protocolos que avalen la inocuidad de los productos, ya que las infecciones por la ingesta de alimentos contaminados ocurren con frecuencia y bacterias del género Salmonella son de los agentes causales más comunes en todo el mundo (Putturu, Eevuri, Ch, & Nelapati, 2015); en EE. UU. se estima que causa alrededor de 26% de las intoxicaciones originadas por alimentos (Nakao et al., 2018). En México se reportan más de 70,000 casos al año; pero es díficil conocer con exactitud las cifras y es un tema de suma importancia para la Secretaría de Salud (Contreras-Soto et al., 2019; Félix-Fuentes et al., 2005).
CONCLUSIONES
El conteo de mesófilos aerobios y mohos se encuentra muy por debajo de los límites permitidos para harinas de cereales que indica la NOM-247-SSA1-2008 (Secretaría de Salud, 27 de julio de 2009). El no haber detectado coliformes totales, fecales, ni levaduras es un aspecto positivo; sin embargo, un hecho preocupante es la detección de Salmonella spp., que como se mencionó anteriormente, al ser un mesófilo aerobio los conteos son muy bajos; pero no debe minimizarse su presencia dado el riesgo que representa para la salud pública. Los procesos de control de calidad y de inocuidad en la producción de estos alimentos debe ser reforzado, ya que esta contaminación pudo haber ocurrido en cualquiera de los eslabones de la cadena de producción y no precisamente provenir del insecto.
Los resultados del estudio contribuyen al conocimiento de los microorganismos que podrían llegar a contaminar productos alimenticios elaborados con base en insectos. Es de suma importancia garantizar la inocuidad de dichos alimentos; tanto por su importancia cultural y nutricional como por la opción que representan para garantizar la seguridad alimentaria. La producción y/o colecta de insectos para consumo humano tiene un impacto económico en ciertas regiones de México y el mundo, es por eso también que debe ponerse especial atención a estudios de este tipo para mejorar los procesos y garantizar la seguridad que brinde confianza a los consumidores para que el mercado crezca.
Los insectos para alimentación humana son una opción viable como fuente de proteína, ácidos grasos saludables, vitaminas y minerales; cuya producción, comparada con otras fuentes de origen animal tiene un impacto negativo mínimo en el medio ambiente; dada la importancia de contar con esta opción ante los retos del futuro; la necesidad de establecer regulaciones legales tanto para la producción, procesamiento, empaque y comercialización de insectos comestibles, como para la conservación y colecta de poblaciones silvestres es urgente. Estudios sobre la inocuidad en el consumo de estos alimentos y sus derivados son necesarios en el mundo y en México para garantizar la seguridad en su consumo.
REFERENCIAS
Akullo, J. O., Kiage‐Mokua, B. N., Nakimbugwe, D., Ng'ang'a, J., & Kinyuru, J. (2023). Color, pH, microbiological, and sensory quality of crickets (Gryllus bimaculatus) flour preserved with ginger and garlic extracts. Food Science & Nutrition, 11(6), 2838-2851. https://doi.org/10.1002/fsn3.3262
Arango-Gutiérrez, G. P., Vergara-Ruiz, R. A., & Mejía-Vélez, H. (2004). Análisis composicional, microbiológico y digestibilidad de la proteína de la harina de larvas de Hermetia illuscens L (Diptera: Stratiomyiidae) en Angelópolis-Antioquia, Colombia. Revista Facultad Nacional de Agronomía Medellin, 57(2), 2491-2499. https://revistas.unal.edu.co/index.php/refame/article/view/24234
Arnaud-López, J. D., Cuateco-Hueyopa, R. I., & Ortega-Morales, D. (2022). Elaboración y caracterización de yogurt fortificado con harina de insecto (Acheta domesticus), sometido a tratamientos térmicos y no térmicos. Expo Ibero Otoño 2022 (12 p.). Universidad Iberoamericana Puebla. https://hdl.handle.net/20.500.11777/5594
Belluco, S., Losasso, C., Maggioletti, M., Alonzi, C. C., Paoletti, M. G., & Ricci, A. (2013). Edible insects in a food safety and nutritional perspective: A critical review. Comprehensive Reviews in Food Science and Food Safety, 12(3), 296-313. https://doi.org/10.1111/1541-4337.12014
Campuzano, S., Mejía Flórez, D., Madero Ibarra, C., & Pabón Sánchez, P. (2015). Determinación de la calidad microbiológica y sanitaria de alimentos preparados vendidos en la vía pública de la ciudad de Bogotá D. C. Nova, 13(23), 81-92. https://doi.org/10.22490/24629448.1708
Caparros-Megido, R., Desmedt, S., Blecker, C., Béra, F., Haubruge, É., Alabi, T., & Francis, F. (2017). Microbiological load of edible insects found in Belgium. Insects, 8(1), 12. https://doi.org/10.3390/insects8010012
Contreras-Soto, M. B., Medrano-Félix, J. A., Ibarra-Rodríguez, J. R., Martínez-Urtaza, J., Chaidez, Q. C., & Castro del Campo, N. (2019). The last 50 years of Salmonella in Mexico: Sources of isolation and factors that influence its prevalence and diversity. Revista Bio Ciencias, 6(especial): Inocuidad Alimentaria, e540. https://doi.org/10.15741/revbio.06.nesp.e540
Corredor-Bejar, S. (2022). Diseño del proceso productivo y construcción de nave de procesado para 45.351 kg/año de insectos comestibles Jalcomulco, Veracruz (México) (Proyecto fin de carrera/Trabajo fin de grado). Universidad Politécnica de Madrid, Madrid.
DeFoliart, G. R. (1991). Insect fatty acids: similar to those of poultry and fish in their degree of unsaturation, but higher in the polyunsaturates. The Food Insects Newsletter, 4(1), 1-4.
Félix-Fuentes, A., Campas-Baypoli, O. N., & Meza-Montenegro, M. (2005). Calidad sanitaria de alimentos disponibles al público de Ciudad Obregón, Sonora, México. RESPYN Revista Salud Pública y Nutrición, 6(3). https://respyn.uanl.mx/index.php/respyn/article/view/149
Fernandez-Cassi, X., Supeanu, A., Vaga, M., Jansson, A., Boqvist, S., & Vagsholm, I. (2019). The house cricket (Acheta domesticus) as a novel food: a risk profile. Journal of Insects as Food and Feed, 5(2), 137-157. https://doi.org/10.3920/JIFF2018.0021
Food and Agriculture Organisation. (2009). How to feed the world in 2050. Insights from an expert meeting (pp. 1-35). Autor. https://www.fao.org/fileadmin/templates/wsfs/docs/expert_paper/How_to_Feed_the_World_in_2050.pdf
Frentzel, H., Kelner-Burgos, Y., Fischer, J., Heise, J., Göhler, A., & Wichmann-Schauer, H. (2022). Occurrence of selected bacterial pathogens in insect-based food products and in-depth characterization of detected Bacillus cereus group isolates. International Journal of Food Microbiology, 379, 109860. https://doi.org/10.1016/j.ijfoodmicro.2022.109860
García-Ramírez, A. G., Valdez-Gutiérrez, L. J., & López-Toledo, S. (2022). Inocuidad alimentaria en la entomofagia: Chapulines (Orthóptera) de Oaxaca, México. Revista Española de Nutrición Comunitaria, 28(4). https://www.renc.es/noticias.asp?cod=80&page=1&sec=22&v=&buscar=
Garofalo, C., Osimani, A., Milanović, V., Taccari, M., Cardinali, F., Aquilanti, L., … Clementi, F. (2017). The microbiota of marketed processed edible insects as revealed by high-throughput sequencing. Food Microbiology, 62, 15-22. https://doi.org/10.1016/j.fm.2016.09.012
Grabowski, N. T., & Klein, G. (2017a). Microbiology of cooked and dried edible Mediterranean field crickets (Gryllus bimaculatus) and superworms (Zophobas atratus) submitted to four different heating treatments. Food Science and Technology International, 23(1), 17-23. https://doi.org/10.1177/1082013216652994
__________ (2017b). Microbiological analysis of raw edible insects. Journal of Insects as Food and Feed, 3(1), 7-14. https://doi.org/10.3920/JIFF2016.0004
Imathiu, S. (2020). Benefits and food safety concerns associated with consumption of edible insects. NFS Journal, 18, 1-11. https://doi.org/10.1016/j.nfs.2019.11.002
Jongema, Y. (2017). List of edible insects of the world [Lista en archivo pdf]. Wageningen University. https://tinyurl.com/y8puwl5q
Köhler, R., Kariuki, L., Lambert, C., & Biesalski, H. K. (2019). Protein, amino acid and mineral composition of some edible insects from Thailand. Journal of Asia-Pacific Entomology, 22(1), 372-378. https://doi.org/10.1016/j.aspen.2019.02.002
Mohammad, A. M., Chowdhury, T., Biswas, B., & Absar, N. (2018). Food poisoning and intoxication: A global leading concern for human health. In A. Grumezescu & A. Holban (Eds.), Food safety and preservation (pp. 307-352). Academic Press.
Müller, A., Seinige, D., Grabowski, N. T., Ahlfeld, B., Yue, M., & Kehrenberg, C. (2021). Characterization of Escherichia coli from Edible Insect Species: Detection of Shiga Toxin-Producing Isolate. Foods, 10(11), 2552. https://doi.org/10.3390/foods10112552
Murefu, T. R., Macheka, L., Musundire, R., & Manditsera, F. A. (2019). Safety of wild harvested and reared edible insects: A review. Food Control, 101, 209-224. https://doi.org/10.1016/j.foodcont.2019.03.003
Nakao, J. H., Talkington, D., Bopp, C. A., Besser, J., Sanchez, M. L., Guarisco, J.,… Wise, M. E. (2018). Unusually high illness severity and short incubation periods in two foodborne outbreaks of Salmonella Heidelberg infections with potential coincident Staphylococcus aureus intoxication. Epidemiology & Infection, 146(1), 19-27. https://doi.org/10.1017/s0950268817002655
Navarro-Cruz, A. R., Ávila-Sosa, S. R., Aguilar-Alonso, P., Vera-López, O., & Dávila-Márquez, R. (2011). Estudio de la composición nutricional de cuchama (Paradirphia fumosa) de la mixteca poblana. Ciencia y Mar XV, 13-21.
Nyangena, D. N., Mutungi, C., Imathiu, S., Kinyuru, J., Affognon, H., Ekesi, S.,… Fiaboe, K. K. (2020). Effects of traditional processing techniques on the nutritional and microbiological quality of four edible insect species used for food and feed in East Africa. Foods, 9(5), 574. https://doi.org/10.3390/foods9050574
Osimani, A., Garofalo, C., Milanović, V., Taccari, M., Cardinali, F., Aquilanti, L.,… Clementi, F. (2017). Insight into the proximate composition and microbial diversity of edible insects marketed in the European Union. European Food Research and Technology, 243, 1157-1171. https://doi.org/10.1007/s00217-016-2828-4
Putturu, R., Eevuri, T., Ch, B., & Nelapati, K. (2015). Salmonella enteritidis-foodborne pathogen-a review. International Journal of Pharmacy and Biological Sciences, 5(1), 86-95.
Ramos-Elorduy, J., Pino, J. M., & Conconi, M. (2006). Ausencia de una reglamentación y normalización de la explotación y comercialización de insectos comestibles en México. Folia Entomológica Mexicana, 45(3), 291-318.
Ramos-Rostro, B., Ramos-Elorduy Blásquez, J., Pino-Moreno, J. M., Viesca-González, F. C., Martínez-Maya, J. J., Sierra-Gómez Pedroso, L. D. C., & Quintero-Salazar, B. (2016). Calidad sanitaria de alimentos elaborados con gusano rojo de agave (Comadia redtembacheri H.) en San Juan Teotihuacán, Estado de México, México. Agrociencia, 50(4), 391-402.
Ritter, K. S. (1990). Cholesterol and Insects. The Food Insects Newsletter, 3(1).
Secretaría de Salud. (13 de septiembre de 1995). Norma Oficial Mexicana NOM-111-SSA1-1994, Bienes y servicios. Método para la cuenta de mohos y levaduras en alimentos. Diario Oficial de la Federación. https://dof.gob.mx/nota_detalle.php?codigo=4881226&fecha=13/09/1995#gsc.tab=0
__________ (22 de septiembre de 1995). Norma Oficial Mexicana NOM-114-SSA1-1994, Bienes y servicios. Método para la determinación de salmonella en alimentos. Diario Oficial de la Federación. https://www.dof.gob.mx/nota_to_imagen_fs.php?codnota=4881851&fecha=22/09/1995&cod_diario=209334
__________ (12 de diciembre de 1995). Norma Oficial Mexicana NOM-092-SSA1-1994, Bienes y servicios. Método para la cuenta de bacterias aerobias en placa. Diario Oficial de la Federación. https://dof.gob.mx/nota_detalle.php?codigo=4886029&fecha=12/12/1995#gsc.tab=0
__________ (27 de julio de 2009). Norma Oficial Mexicana NOM-247-SSA1-2008, Productos y servicios. Cereales y sus productos. Cereales, harinas de cereales, sémolas o semolinas. Alimentos a base de: cereales, semillas comestibles, de harinas, sémolas o semolinas o sus mezclas. Productos de panificación. Disposiciones y especificaciones sanitarias y nutrimentales. Métodos de prueba. Diario Oficial de la Federación. https://dof.gob.mx/nota_detalle.php?codigo=5100356&fecha=27/07/2009#gsc.tab=0
Van der Fels‐Klerx, H. J., Camenzuli, L., Belluco, S., Meijer, N., & Ricci, A. (2018). Food safety issues related to uses of insects for feeds and foods. Comprehensive Reviews in Food Science and Food Safety, 17(5), 1172-1183. https://doi.org/10.1111/1541-4337.12385
Van Huis, A. (2015). Edible insects contributing to food security? Agriculture & Food Security, 4, 1-9. https://doi.org/10.1186/s40066-015-0041-5
Vandeweyer, D., Crauwels, S., Lievens, B., & Van Campenhout, L. (2017). Microbial counts of mealworm larvae (Tenebrio molitor) and crickets (Acheta domesticus and Gryllodes sigillatus) from different rearing companies and different production batches. International Journal of Food Microbiology, 242, 13-18. https://doi.org/10.1016/j.ijfoodmicro.2016.11.007
Viesca González, F. C., & Romero Contreras, A. T. (2009). La entomofagia en México. Algunos aspectos culturales. EL PERIPLO SUSTENTABLE, 16, 57-83. https://rperiplo.uaemex.mx/article/view/5039
Notas de autor
yisa8a@yahoo.com
Información adicional
redalyc-journal-id: 674
